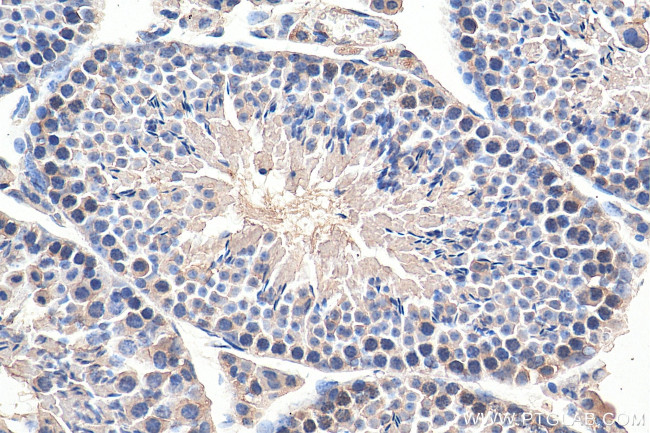
XRCC3 Antibody in Immunohistochemistry (Paraffin) (IHC (P))

Search
Proteintech
XRCC3 Monoclonal Antibody (3A12F9)
{{$productOrderCtrl.translations['antibody.pdp.commerceCard.promotion.promotions']}}
{{$productOrderCtrl.translations['antibody.pdp.commerceCard.promotion.viewpromo']}}
{{$productOrderCtrl.translations['antibody.pdp.commerceCard.promotion.promocode']}}: {{promo.promoCode}} {{promo.promoTitle}} {{promo.promoDescription}}. {{$productOrderCtrl.translations['antibody.pdp.commerceCard.promotion.learnmore']}}
产品信息
67222-1-IG
种属反应
宿主/亚型
分类
类型
克隆号
抗原
偶联物
形式
浓度
纯化类型
保存液
内含物
保存条件
运输条件
产品详细信息
Aliquoting is unnecessary for -20°C storage.
靶标信息
This gene encodes a member of the RecA/Rad51-related protein family that participates in homologous recombination to maintain chromosome stability and repair DNA damage. This gene functionally complements Chinese hamster irs1SF, a repair-deficient mutant that exhibits hypersensitivity to a number of different DNA-damaging agents and is chromosomally unstable. A rare microsatellite polymorphism in this gene is associated with cancer in patients of varying radiosensitivity. Alternatively spliced transcript variants encoding the same protein have been identified.
仅用于科研。不用于诊断过程。未经明确授权不得转售。
篇参考文献 (0)
生物信息学
蛋白别名: DNA repair protein XRCC3; RAD51 like; X-ray repair complementing defective repair in Chinese hamster cells 3; X-ray repair cross-complementing protein 3; XRCC 3
基因别名: 4432412E01Rik; AI182522; AW537713; CMM6; XRCC3
UniProt ID: (Human) O43542, (Mouse) Q9CXE6
Entrez Gene ID: (Human) 7517, (Mouse) 74335